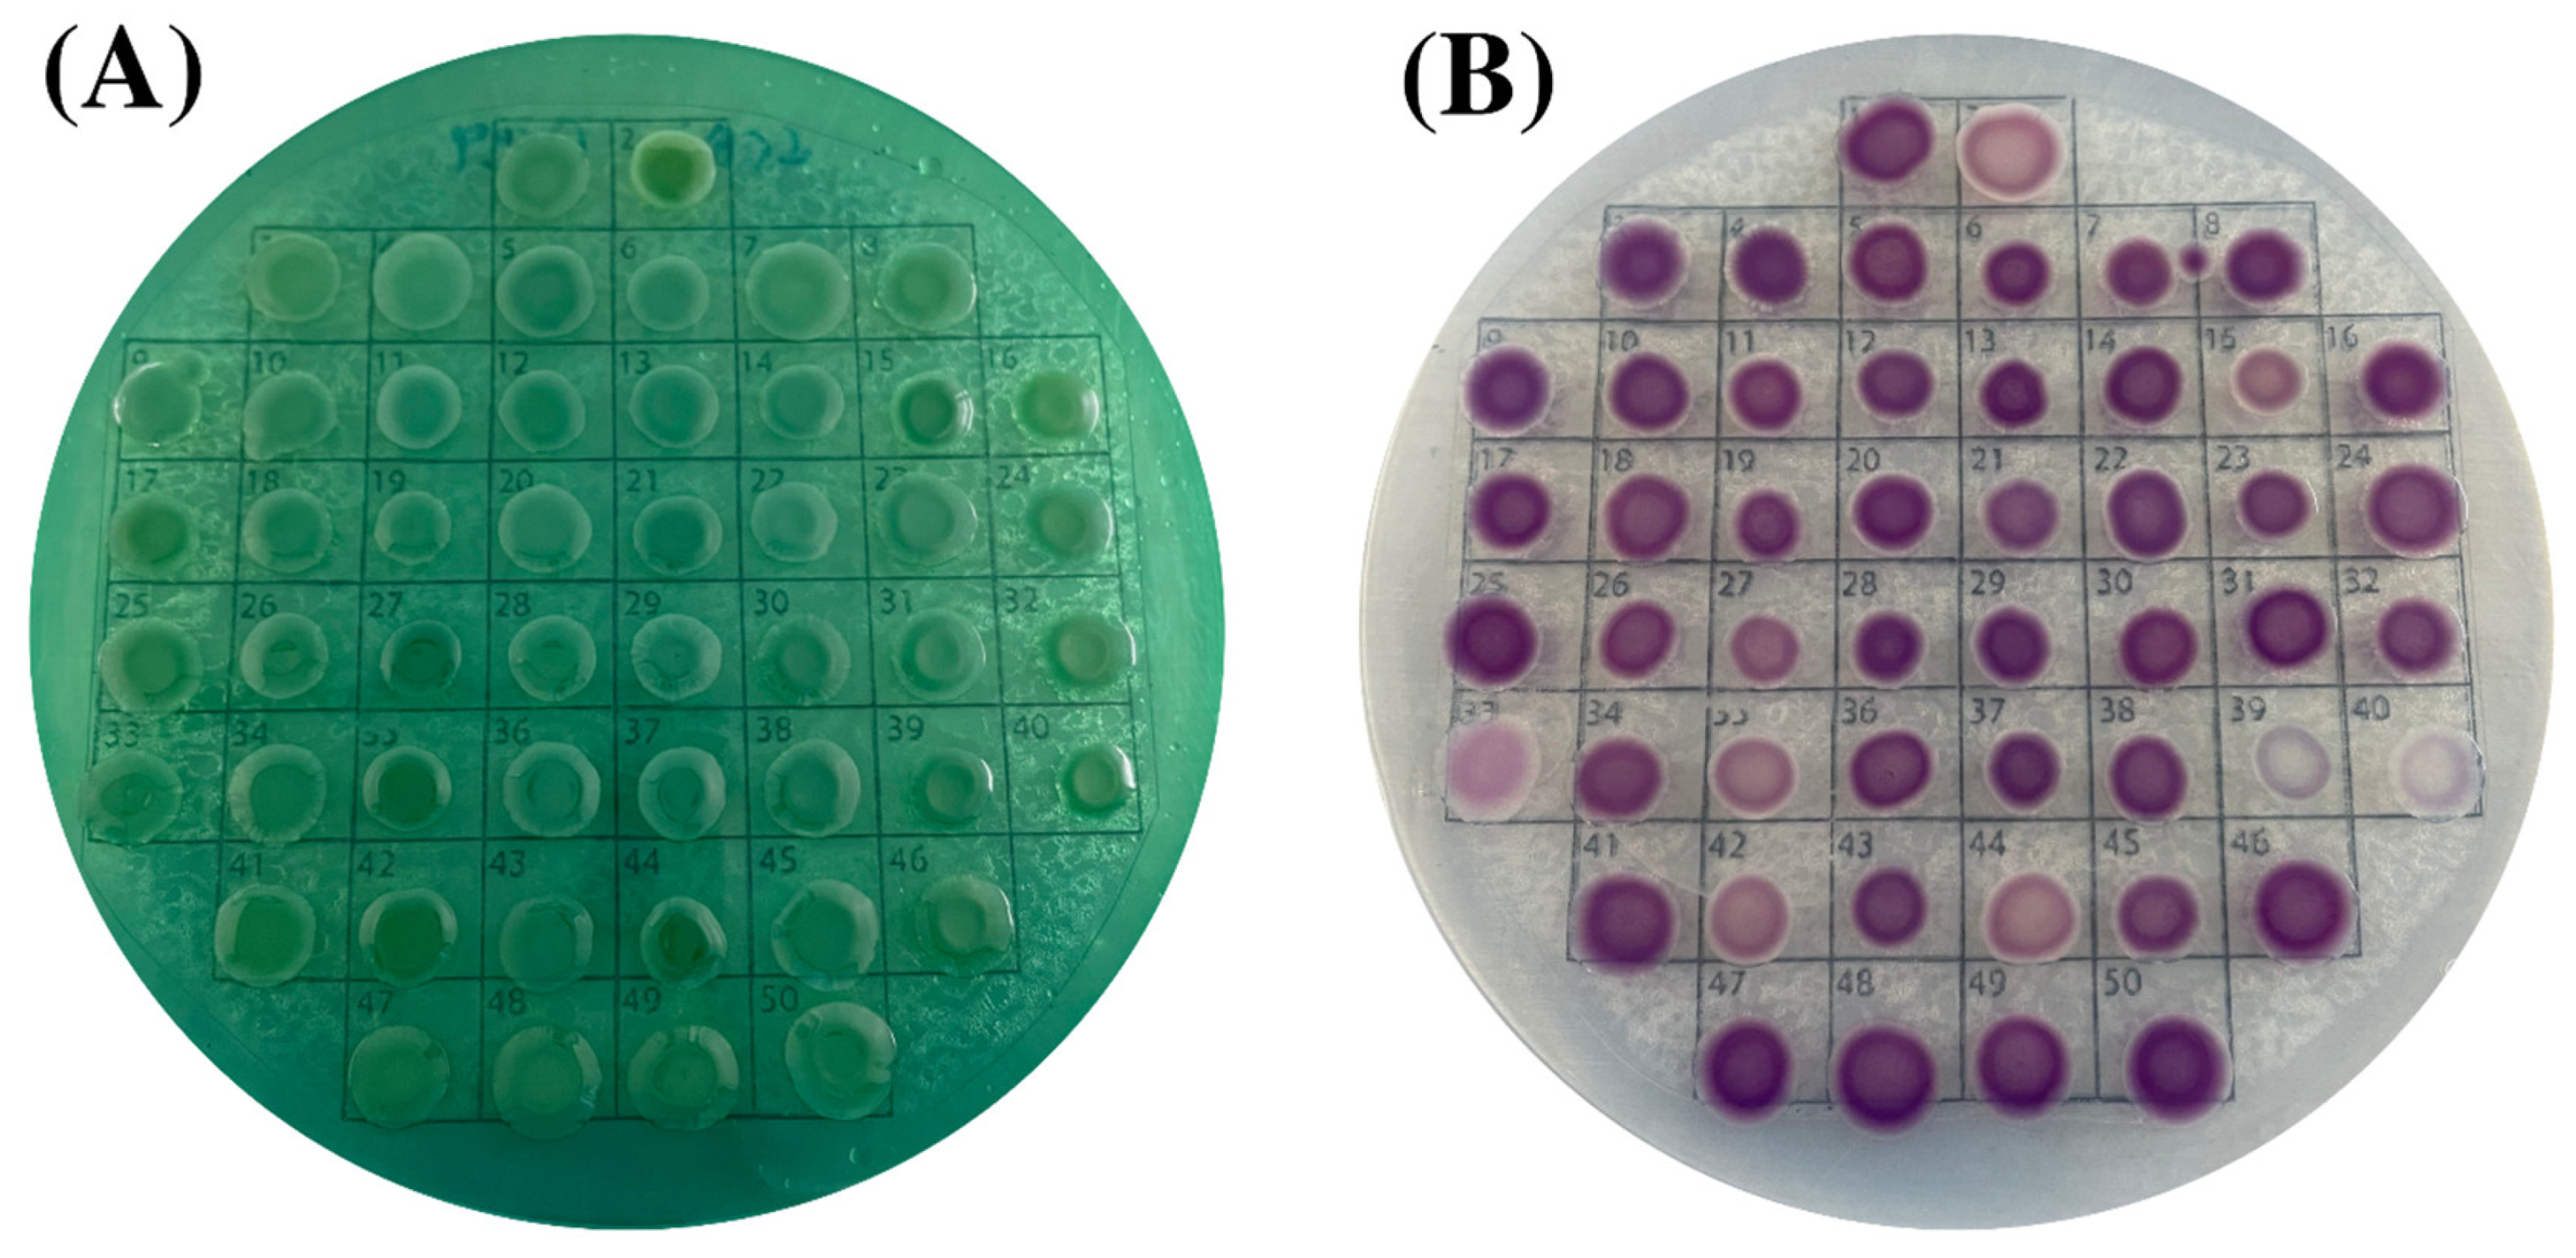
Foods 11 04048 g002

Vibrio parahaemolyticus Isolates from Asian Green Mussel: Molecular Characteristics, Virulence and Their Inhibition by Chitooligosaccharide-Tea Polyphenol Conjugates
Abstract
1. Introduction
2. Materials and Methods
2.1. Sample Collection and Bacterial Isolation
2.2. Polymerase Chain Reaction (PCR) Assay
2.3. Preparation of COS-Tea Polyphenol Conjugates Using Free Radical Grafting Method
2.4. Determination of Minimum Inhibitory Concentration (MIC) and Minimum Bactericidal Concentration (MBC)
2.5. Biofilm Crystal Violet (CV) Staining
2.6. Analysis of Swimming and Swarming Motility
2.7. Kanagawa Phenomenon (KP) Test
2.8. Antibiotic Susceptibility Testing
2.9. Statistical Analyses
3. Results and Discussion
3.1. Characteristics of V. parahaemolyticus Isolates
3.2. Virulence, Molecular and Biochemical Characteristics of V. parahaemolyticus Isolates
3.2.1. Virulence Genes
3.2.2. Hemolytic Activity
3.2.3. Motility Ability
3.2.4. Biofilm Formation Capacity
3.3. Antimicrobial Activity of COS-Tea Polyphenol Conjugates toward V. parahaemolyticus Isolates
3.4. Antibiotic Susceptibility Profile of Different V. parahaemolyticus Isolates
4. Conclusions
Author Contributions
Funding
Data Availability Statement
Acknowledgments
Conflicts of Interest
References
- Eli, J.; Exue, F.; Eyang, Z.; Ezhang, X.; Ezeng, D.; Echao, G.; Ejiang, Y.; Eli, B. Vibrio parahaemolyticus Strains of Pandemic Serotypes Identified from Clinical and Environmental Samples from Jiangsu, China. Front. Microbiol. 2016, 7, 787. [Google Scholar] [CrossRef]
- Liu, H.; Wang, Y.; Cao, J.; Jiang, H.; Yao, J.; Gong, G.; Chen, X.; Xu, W.; He, X. Antimicrobial activity and virulence attenuation of citral against the fish pathogen Vibrio alginolyticus. Aquaculture 2020, 515, 734578. [Google Scholar] [CrossRef]
- Kaneko, T.; Colwell, R.R. Ecology of Vibrio parahaemolyticus in Chesapeake Bay. J. Bacteriol. 1973, 113, 24–32. [Google Scholar] [CrossRef] [PubMed]
- Givens, C.E.; Bowers, J.C.; DePaola, A.; Hollibaugh, J.T.; Jones, J.L. Occurrence and distribution of Vibrio vulnificus and Vibrio parahaemolyticus—Potential roles for fish, oyster, sediment and water. Lett. Appl. Microbiol. 2014, 58, 503–510. [Google Scholar] [CrossRef]
- Mahmoud, B.S. The efficacy of grape seed extract, citric acid and lactic acid on the inactivation of Vibrio parahaemolyticus in shucked oysters. Food Control 2014, 41, 13–16. [Google Scholar] [CrossRef]
- Odeyemi, O.A. Incidence and prevalence of Vibrio parahaemolyticus in seafood: A systematic review and meta-analysis. Springerplus 2016, 5, 464. [Google Scholar] [CrossRef]
- Froelich, B.A.; Phippen, B.; Fowler, P.; Noble, R.T.; Oliver, J.D. Differences in Abundances of Total Vibrio spp., V. vulnificus, and V. parahaemolyticus in Clams and Oysters in North Carolina. Appl. Environ. Microbiol. 2017, 83, e02265-16. [Google Scholar] [CrossRef]
- Paranjpye, R.N.; Nilsson, W.B.; Liermann, M.; Hilborn, E.D.; George, B.J.; Li, Q.; Bill, B.D.; Trainer, V.L.; Strom, M.S.; Sandifer, P.A. Environmental influences on the seasonal distribution of Vibrio parahaemolyticus in the Pacific Northwest of the USA. FEMS Microbiol. Ecol. 2015, 91, fiv121. [Google Scholar] [CrossRef]
- Letchumanan, V.; Pusparajah, P.; Tan, T.H.; Yin, W.F.; Lee, L.H.; Chan, K.G. Occurrence and Antibiotic Resistance of V. para-haemolyticus from Shellfish in Selangor, Malaysia. Front. Microbiol. 2015, 6, 1417. [Google Scholar] [CrossRef]
- Eschbach, E.; Martin, A.; Huhn, J.; Seidel, C.; Heuer, R.; Schumacher, J.-H.; Ulrich, S.; Axe, J.-O.; Konietzny, A.; Strauch, E.; et al. Detection of enteropathogenic Vibrio parahaemolyticus, Vibrio cholerae and Vibrio vulnificus: Performance of real-time PCR kits in an interlaboratory study. Eur. Food Res. Technol. 2017, 243, 1335–1342. [Google Scholar] [CrossRef]
- Altekruse, S.F.; Bishop, R.D.; Baldy, L.M.; Thompson, S.G.; Wilson, S.A.; Ray, B.J.; Griffin, P.M. Vibrio gastroenteritis in the US Gulf of Mexico region: The role of raw oysters. Epidemiol. Infect. 2000, 124, 489–495. [Google Scholar] [CrossRef]
- Baker-Austin, C.; Oliver, J.D.; Alam, M.; Ali, A.; Waldor, M.K.; Qadri, F.; Martinez-Urtaza, J. Vibrio spp. infections. Nat. Rev. Dis. Primers 2018, 4, 1–19. [Google Scholar] [CrossRef]
- West, C.K.G.; Klein, S.L.; Lovell, C.R. High Frequency of Virulence Factor Genes tdh, trh, and tlh in Vibrio parahaemolyticus Strains Isolated from a Pristine Estuary. Appl. Environ. Microbiol. 2013, 79, 2247–2252. [Google Scholar] [CrossRef]
- Yan, J.; Nadell, C.D.; Stone, H.A.; Wingreen, N.S.; Bassler, B.L. Extracellular-matrix-mediated osmotic pressure drives Vibrio cholerae biofilm expansion and cheater exclusion. Nat. Commun. 2017, 8, 327. [Google Scholar] [CrossRef]
- Siddall, S.E. A Clarification of the Genus Perna (Mytilidae). Bull. Mar. Sci. 1980, 30, 858–870. [Google Scholar]
- Rajagopal, S.; Venugopalan, V.P.; van der Velde, G.; Jenner, H.A. Greening of the coasts: A review of the Perna viridis success story. Aquat. Ecol. 2006, 40, 273–297. [Google Scholar] [CrossRef]
- Nakaguchi, Y. Contamination by Vibrio parahaemolyticus and Its Virulent Strains in Seafood Marketed in Thailand, Vietnam, Malaysia, and Indonesia. Trop. Med. Health 2013, 41, 95–102. [Google Scholar] [CrossRef]
- Cruz, C.D.; Hedderley, D.; Fletcher, G.C. Long-Term Study of Vibrio parahaemolyticus Prevalence and Distribution in New Zealand Shellfish. Appl. Environ. Microbiol. 2015, 81, 2320–2327. [Google Scholar] [CrossRef]
- World Health Organization (WHO). Antimicrobial Resistance: Global Report on Surveillance. 2014. Available online: http://apps.who.int/iris/bitstream/handle/10665/112642/9789241564748_eng.pdf (accessed on 15 January 2019).
- Singh, A.; Benjakul, S.; Huda, N.; Xu, C.; Wu, P. Preparation and characterization of squid pen chitooligosaccharide–epigallocatechin gallate conjugates and their antioxidant and antimicrobial activities. RSC Adv. 2020, 10, 33196–33204. [Google Scholar] [CrossRef]
- Mittal, A.; Singh, A.; Zhang, B.; Visessanguan, W.; Benjakul, S. Chitooligosaccharide Conjugates Prepared Using Several Phenolic Compounds via Ascorbic Acid/H2O2 Free Radical Grafting: Characteristics, Antioxidant, Antidiabetic, and Antimicrobial Activities. Foods 2022, 11, 920. [Google Scholar] [CrossRef]
- Eom, T.-K.; Senevirathne, M.; Kim, S.-K. Synthesis of phenolic acid conjugated chitooligosaccharides and evaluation of their antioxidant activity. Environ. Toxicol. Pharmacol. 2012, 34, 519–527. [Google Scholar] [CrossRef] [PubMed]
- Chatterjee, N.S.; Panda, S.K.; Navitha, M.; Asha, K.; Anandan, R.; Mathew, S. Vanillic Acid and Coumaric Acid Grafted Chitosan Derivatives: Improved Grafting Ratio and Potential Application in Functional Food. J. Food Sci. Technol. 2015, 52, 7153–7162. [Google Scholar] [CrossRef]
- Park, H.-H.; Ko, S.-C.; Oh, G.-W.; Jang, Y.-M.; Kim, Y.-M.; Park, W.S.; Choi, I.-W.; Jung, W.-K. Characterization and biological activity of PVA hydrogel containing chitooligosaccharides conjugated with gallic acid. Carbohydr. Polym. 2018, 198, 197–205. [Google Scholar] [CrossRef] [PubMed]
- Moussa, M.; Cauvin, E.; Le Piouffle, A.; Lucas, O.; Bidault, A.; Paillard, C.; Benoit, F.; Thuillier, B.; Treilles, M.; Travers, M.A.; et al. A MALDI-TOF MS database for fast identification of Vibrio spp. potentially pathogenic to marine mollusks. Appl. Microbiol. Biotechnol. 2021, 105, 2527–2539. [Google Scholar] [CrossRef] [PubMed]
- ISO 21872-1:2017; Microbiology of the Food Chain—Horizontal Method for the Determination of Vibrio Spp.—Part 1, Detection of Potentially Enteropathogenic V. parahaemolyticus, Vibrio cholerae and Vibrio vulnificus. International Organization for Standardization: Geneva, Switzerland, 2017.
- Siddique, A.B.; Moniruzzaman, M.; Ali, S.; Dewan, N.; Islam, M.R.; Islam, S.; Amin, M.B.; Mondal, D.; Parvez, A.K.; Mahmud, Z.H. Characterization of Pathogenic Vibrio parahaemolyticus Isolated From Fish Aquaculture of the Southwest Coastal Area of Bangladesh. Front. Microbiol. 2021, 12, 635539. [Google Scholar] [CrossRef]
- Singh, A.; Mittal, A.; Benjakul, S. Chitosan, Chitooligosaccharides and Their Polyphenol Conjugates: Preparation, Bioactivities, Functionalities and Applications in Food Systems. Food Rev. Int. 2021, 1–23. [Google Scholar] [CrossRef]
- Herigstad, B.; Hamilton, M.; Heersink, J. How to optimize the drop plate method for enumerating bacteria. J. Microbiol. Methods 2001, 44, 121–129. [Google Scholar] [CrossRef]
- Wang, L.; Ling, Y.; Jiang, H.; Qiu, Y.; Qiu, J.; Chen, H.; Yang, R.; Zhou, D. AphA is required for biofilm formation, motility, and virulence in pandemic Vibrio parahaemolyticus. Int. J. Food Microbiol. 2013, 160, 245–251. [Google Scholar] [CrossRef]
- Fang, M.; Wang, R.; Agyekumwaa, A.K.; Yu, Y.; Xiao, X. Antibacterial effect of phenyllactic acid against Vibrio parahaemolyticus and its application on raw salmon fillets. LWT 2022, 154, 112586. [Google Scholar] [CrossRef]
- Zhang, Y.; Hu, L.; Osei-Adjei, G.; Zhang, Y.; Yang, W.; Yin, Z.; Lu, R.; Sheng, X.; Yang, R.; Huang, X.; et al. Autoregulation of ToxR and Its Regulatory Actions on Major Virulence Gene Loci in Vibrio parahaemolyticus. Front. Cell. Infect. Microbiol. 2018, 8, 291. [Google Scholar] [CrossRef]
- Shaw, K.S.; Goldstein, R.E.R.; He, X.; Jacobs, J.M.; Crump, B.C.; Sapkota, A.R. Antimicrobial Susceptibility of Vibrio vulnificus and Vibrio parahaemolyticus Recovered from Recreational and Commercial Areas of Chesapeake Bay and Maryland Coastal Bays. PLoS ONE 2014, 9, e89616. [Google Scholar] [CrossRef]
- CLSI. Methods for Antimicrobial Dilution and Disk Susceptibility Testing of Infrequently Isolated or Fastidious Bacteria; Approved Guideline-Second Edition (M45-A2); Clinical and Laboratory Standards Institute: Wayne, PA, USA, 2010. [Google Scholar]
- Krumperman, P.H. Multiple antibiotic resistance indexing of Escherichia coli to identify high-risk sources of fecal contamination of foods. Appl. Environ. Microbiol. 1983, 46, 165–170. [Google Scholar] [CrossRef]
- Lee, J.-M.; Azizah, R.N.; Kim, K.-S. Comparative evaluation of three agar media-based methods for presumptive identification of seafood-originated Vibrio parahaemolyticus strains. Food Control 2020, 116, 107308. [Google Scholar] [CrossRef]
- Su, Y.-C.; Duan, J.; Wu, W.-H. Selectivity and Specificity of a Chromogenic Medium for Detecting Vibrio parahaemolyticus. J. Food Prot. 2005, 68, 1454–1456. [Google Scholar] [CrossRef]
- Beleneva, I.A.; Maslennikova, E.F.; Magarlamov, T.Y. Physiological and Biochemical Characteristics of the Halophilic Bacteria Vibrio parahaemolyticus and V. alginolyticus Isolated from Marine Invertebrates of Peter the Great Bay, Sea of Japan. Russ. J. Mar. Biol. 2004, 30, 96–100. [Google Scholar] [CrossRef]
- Tan, C.W.; Malcolm, T.T.H.; Kuan, C.H.; Thung, T.Y.; Chang, W.S.; Loo, Y.Y.; Premarathne, J.M.K.J.K.; Ramzi, O.B.; Norshafawatie, M.F.S.; Yusralimuna, N.; et al. Prevalence and Antimicrobial Susceptibility of Vibrio parahaemolyticus Isolated from Short Mackerels (Rastrelliger brachysoma) in Malaysia. Front. Microbiol. 2017, 8, 1087. [Google Scholar] [CrossRef]
- Kang, C.-H.; Shin, Y.; Jang, S.; Yu, H.; Kim, S.; An, S.; Park, K.; So, J.-S. Characterization of Vibrio parahaemolyticus isolated from oysters in Korea: Resistance to various antibiotics and prevalence of virulence genes. Mar. Pollut. Bull. 2017, 118, 261–266. [Google Scholar] [CrossRef]
- Jiang, Y.; Chu, Y.; Xie, G.; Li, F.; Wang, L.; Huang, J.; Zhai, Y.; Yao, L. Antimicrobial resistance, virulence and genetic relationship of Vibrio parahaemolyticus in seafood from coasts of Bohai Sea and Yellow Sea, China. Int. J. Food Microbiol. 2019, 290, 116–124. [Google Scholar] [CrossRef]
- Mok, J.S.; Ryu, A.; Kwon, J.Y.; Kim, B.; Park, K. Distribution of Vibrio species isolated from bivalves and bivalve culture environments along the Gyeongnam coast in Korea: Virulence and antimicrobial resistance of Vibrio parahaemolyticus isolates. Food Control 2019, 106, 106697. [Google Scholar] [CrossRef]
- Rodriguez-Castro, A.; Ansede-Bermejo, J.; Blanco-Abad, V.; Varela-Pet, J.; Garcia-Martin, O.; Martinez-Urtaza, J. Prevalence and Genetic Diversity of Pathogenic Populations of Vibrio parahaemolyticus in Coastal Waters of Galicia, Spain. Environ. Microbiol. Rep. 2010, 2, 58–66. [Google Scholar] [CrossRef]
- Bhoopong, P.; Palittapongarnpim, P.; Pomwised, R.; Kiatkittipong, A.; Kamruzzaman, M.; Nakaguchi, Y.; Nishibuchi, M.; Ishibashi, M.; Vuddhakul, V. Variability of Properties of Vibrio parahaemolyticus Strains Isolated from Individual Patients. J. Clin. Microbiol. 2007, 45, 1544–1550. [Google Scholar] [CrossRef] [PubMed][Green Version]
- Chen, Y.; Chen, X.; Yu, F.; Wu, M.; Wang, R.; Zheng, S.; Han, D.; Yang, Q.; Kong, H.; Zhou, F.; et al. Serology, virulence, antimicrobial susceptibility and molecular characteristics of clinical Vibrio parahaemolyticus strains circulating in southeastern China from 2009 to 2013. Clin. Microbiol. Infect. 2016, 22, 258.e9–258.e16. [Google Scholar] [CrossRef] [PubMed]
- Raghunath, P. Roles of Thermostable Direct Hemolysin (TDH) and TDH-Related Hemolysin (TRH) in V. parahaemolyticus. Front. Microbiol. 2015, 5, 805. [Google Scholar] [CrossRef] [PubMed]
- Lee, C.-Y.; Cheng, M.-F.; Yu, M.-S.; Pan, M.-J. Purification and characterization of a putative virulence factor, serine protease, from Vibrio parahaemolyticus. FEMS Microbiol. Lett. 2002, 209, 31–37. [Google Scholar] [CrossRef] [PubMed]
- McCarter, L.L. Dual Flagellar Systems Enable Motility under Different Circumstances. Microb. Physiol. 2004, 7, 18–29. [Google Scholar] [CrossRef]
- Yildiz, F.H.; Visick, K.L. Vibrio biofilms: So much the same yet so different. Trends Microbiol. 2009, 17, 109–118. [Google Scholar] [CrossRef]
- Simões, M.; Cleto, S.; Pereira, M.O.; Vieira, M.J. Influence of Biofilm Composition on the Resistance to Detachment. Water Sci. Technol. 2007, 55, 473–480. [Google Scholar] [CrossRef]
- Flemming, H.C.; Wingender, J. The Biofilm Matrix. Nat. Rev. Microbiol. 2010, 8, 623–633. [Google Scholar] [CrossRef]
- Mizan, M.F.R.; Jahid, I.K.; Ha, S.-D. Microbial Biofilms in Seafood: A Food-Hygiene Challenge. Food Microbiol. 2015, 49, 41–55. [Google Scholar] [CrossRef]
- Ashrafudoulla, M.; Mizan, F.R.; Park, S.H.; Ha, S.-D. Current and future perspectives for controlling Vibrio biofilms in the seafood industry: A comprehensive review. Crit. Rev. Food Sci. Nutr. 2021, 61, 1827–1851. [Google Scholar] [CrossRef]
- Sun, J.; Li, X.; Hu, Z.; Xue, X.; Zhang, M.; Wu, Q.; Zhang, W.; Zhang, Y.; Lu, R. Characterization of Vibrio parahaemolyticus isolated from stool specimens of diarrhea patients in Nantong, Jiangsu, China during 2018–2020. PLoS ONE 2022, 17, e0273700. [Google Scholar] [CrossRef]
- Song, X.; Ma, Y.; Fu, J.; Zhao, A.; Guo, Z.; Malakar, P.K.; Pan, Y.; Zhao, Y. Effect of temperature on pathogenic and non-pathogenic Vibrio parahaemolyticus biofilm formation. Food Control 2017, 73, 485–491. [Google Scholar] [CrossRef]
- Ahmed, H.A.; El Bayomi, R.M.; Hussein, M.A.; Khedr, M.H.; Remela, E.M.A.; El-Ashram, A.M. Molecular characterization, antibiotic resistance pattern and biofilm formation of Vibrio parahaemolyticus and V. cholerae isolated from crustaceans and humans. Int. J. Food Microbiol. 2018, 274, 31–37. [Google Scholar] [CrossRef]
- Elexson, N.; Yaya, R.; Nor, A.M.; Kantilal, H.K.; Son, R. Biofilm Assessment of V. parahaemolyticus from Seafood Using Random Amplified Polymorphism DNA-PCR. Int. Food Res. J. 2014, 21, 59–65. [Google Scholar]
- Goy, R.C.; Morais, S.T.; Assis, O.B. Evaluation of the antimicrobial activity of chitosan and its quaternized derivative on E. coli and S. aureus growth. Rev. Bras. Farm. 2016, 26, 122–127. [Google Scholar] [CrossRef]
- Sun, X.-H.; Hao, L.-R.; Xie, Q.-C.; Lan, W.-Q.; Zhao, Y.; Pan, Y.-J.; Wu, V.C. Antimicrobial effects and membrane damage mechanism of blueberry (Vaccinium corymbosum L.) extract against Vibrio parahaemolyticus. Food Control 2020, 111, 107020. [Google Scholar] [CrossRef]
- CLSI. M100: Performance Standards for Antimicrobial Susceptibility Testing, 32nd ed.; Clinical and Laboratory Standards Institute: Wayne, PA, USA, 2022. [Google Scholar]

| Provinces | Types of Places Collected | Number of Samples |
|---|---|---|
| Suratthani | Local market | 2 |
| Asian green mussel farm | 6 | |
| Natural habitat | 4 | |
| Trang | Local market | 2 |
| Asian green mussel farm | 4 | |
| Natural habitat | 2 | |
| Songkhla | Local market | 8 |
| Primer | Sequence (5′-3′) | Amplicon Size (bp) | Reference | |
|---|---|---|---|---|
| tlh | F | AAA GCG GAT TAT GCA GAA GCA CTG | 450 | Siddique et al. [27] |
| R | GCT ACT TTC TAG CAT TTT CTC TGC | |||
| tdh | F | CCA TCT GTC CCT TTT CCT GCC | 269 | Siddique et al. [27] |
| R | CCA CTA CCA CTC TCA TAT GC | |||
| trh | F | TTG GCT TCG ATA TTT TCA GTA TCT | 500 | Siddique et al. [27] |
| R | CAT AAC AAA CAT ATG CCC ATT TCC G |
| Bacterial Strains | COS-CAT (mg/mL) | COS-EGCG (mg/mL) | ||
|---|---|---|---|---|
| MIC | MBC | MIC | MBC | |
| VP PSU.SCB.16S.14 | 0.256 | 1.024 | 0.064 | 1.024 |
| M1 | 0.256 | 1.024 | 0.128 | 1.024 |
| M42 | 0.256 | 1.024 | 0.128 | 1.024 |
| M77 | 0.256 | 1.024 | 0.128 | 1.024 |
| M91 | 0.256 | 1.024 | 0.128 | 1.024 |
| M92 | 0.256 | 1.024 | 0.128 | 1.024 |
| M106 | 0.256 | 1.024 | 0.128 | 1.024 |
| HVP1 | 0.256 | 1.024 | 0.128 | 1.024 |
| Antibiotics | Concentration (μg/mL) | VP | M1 | M42 | M77 | M91 | M92 | M106 | HVP1 |
|---|---|---|---|---|---|---|---|---|---|
| Amikacin | 8–32 | S | S | S | S | S | S | S | S |
| Amoxicillin/Clavulanic acid | 4/2–16/8 | S | S | S | S | S | S | S | R |
| Ampicillin | 8–16 | NI | NI | NI | NI | NI | NI | NI | NI |
| Ampicillin/Sulbactam | 4/2–16/8 | S | S | S | S | S | S | S | R |
| Cefepime | 1–32 | S | S | S | S | S | S | S | R |
| Cefotaxime | 1–32 | S | S | S | S | S | S | S | R |
| Cefoxitin | 4–16 | NI | NI | NI | NI | NI | NI | NI | NI |
| Ceftazidime | 1–32 | S | S | S | S | S | S | S | R |
| Ceftriaxone | 0.5–32 | NI | NI | NI | NI | NI | NI | NI | NI |
| Cefuroxime | 8–16 | S | S | I | S | S | S | S | R |
| Ciprofloxacin | 0.06–2 | S | S | S | S | S | S | S | S |
| Colistin | 1–8 | NI | NI | NI | NI | NI | NI | NI | NI |
| Doripenem | 0.5–16 | NI | NI | NI | NI | NI | NI | NI | NI |
| Ertapenem | 0.5–4 | NI | NI | NI | NI | NI | NI | NI | NI |
| Gentamicin | 2–8 | S | S | S | S | S | S | S | S |
| Imipenem | 0.5–16 | S | S | S | S | S | S | S | S |
| Levofloxacin | 0.06–8 | S | S | S | S | S | S | S | S |
| Meropenem | 0.5–16 | S | S | S | S | S | S | S | R |
| Netilmicin | 8–16 | NI | NI | NI | NI | NI | NI | NI | NI |
| Piperacillin/Tazobactam | 8/4–64/4 | S | S | S | S | S | S | S | R |
| Trimethoprim/Sulfamethoxazole | 1/19–4/76 | S | S | S | S | S | S | S | R |
Publisher’s Note: MDPI stays neutral with regard to jurisdictional claims in published maps and institutional affiliations. |
© 2022 by the authors. Licensee MDPI, Basel, Switzerland. This article is an open access article distributed under the terms and conditions of the Creative Commons Attribution (CC BY) license (https://creativecommons.org/licenses/by/4.0/).
Share and Cite
Palamae, S.; Mittal, A.; Yingkajorn, M.; Saetang, J.; Buatong, J.; Tyagi, A.; Singh, P.; Benjakul, S. Vibrio parahaemolyticus Isolates from Asian Green Mussel: Molecular Characteristics, Virulence and Their Inhibition by Chitooligosaccharide-Tea Polyphenol Conjugates. Foods 2022, 11, 4048. https://doi.org/10.3390/foods11244048
Palamae S, Mittal A, Yingkajorn M, Saetang J, Buatong J, Tyagi A, Singh P, Benjakul S. Vibrio parahaemolyticus Isolates from Asian Green Mussel: Molecular Characteristics, Virulence and Their Inhibition by Chitooligosaccharide-Tea Polyphenol Conjugates. Foods. 2022; 11(24):4048. https://doi.org/10.3390/foods11244048
Chicago/Turabian StylePalamae, Suriya, Ajay Mittal, Mingkwan Yingkajorn, Jirakrit Saetang, Jirayu Buatong, Anuj Tyagi, Prabjeet Singh, and Soottawat Benjakul. 2022. "Vibrio parahaemolyticus Isolates from Asian Green Mussel: Molecular Characteristics, Virulence and Their Inhibition by Chitooligosaccharide-Tea Polyphenol Conjugates" Foods 11, no. 24: 4048. https://doi.org/10.3390/foods11244048
APA StylePalamae, S., Mittal, A., Yingkajorn, M., Saetang, J., Buatong, J., Tyagi, A., Singh, P., & Benjakul, S. (2022). Vibrio parahaemolyticus Isolates from Asian Green Mussel: Molecular Characteristics, Virulence and Their Inhibition by Chitooligosaccharide-Tea Polyphenol Conjugates. Foods, 11(24), 4048. https://doi.org/10.3390/foods11244048

